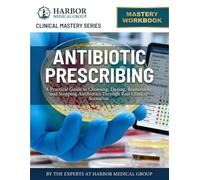
Antibiotic Prescribing: A Practical Guide to Choosing, Dosing, Reassessing, and Stopping Antibiotics Through Real Clinical Scenarios

£30.00
Amazon-marketplace.co.uk
Delivery from £6.75

£24.33
amazon.co.uk
Free Delivery

£15.66
amazon.co.uk
Free Delivery

£13.17
Amazon-marketplace.co.uk
Free Delivery

£14.99
amazon.co.uk
Free Delivery

£16.41
Amazon-marketplace.co.uk
Delivery from £7.74

£8.95
amazon.co.uk
Delivery from £2.99

£9.78
Amazon-marketplace.co.uk
Free Delivery

PHARMACOGENOMICS IN CLINICAL PRACTICE: A Practical Guide to Genotype-Guided Dosing, Drug Response, and Precision Prescribing
£185.56
amazon.co.uk
Free Delivery

£17.74
Amazon-marketplace.co.uk
Delivery from £2.80

ANTIMICROBIAL STEWARDSHIP IN COMMUNITY PRACTICE: Evidence-Based Antibiotic Prescribing, Resistance Prevention, and Practical Stewardship Strategies ... Pharmacists, and Community Health Teams
£170.23
amazon.co.uk
Free Delivery

£41.45
amazon.co.uk
Free Delivery
Antibiotic Prescribing: A Practical Guide to Choosing, Dosing, Reassessing, and Stopping Antibiotics Through Real Clinical Scenarios
£10.37
amazon.co.uk
Free Delivery

£42.41
Amazon-marketplace.co.uk
Free Delivery

£23.83
amazon.co.uk
Free Delivery

£27.40
Amazon-marketplace.co.uk
Delivery from £2.99

Oxford Handbook of Practical Drug Therapy
£32.29
Whsmith.co.uk
Free Delivery

£37.83
Amazon-marketplace.co.uk
Delivery from £2.80

The Frith Prescribing Guidelines for People with Intellectual Disability
£37.99
Whsmith.co.uk
Free Delivery

£26.80
amazon.co.uk
Free Delivery

£9.99
Amazon-marketplace.co.uk
Delivery from £3.99

Handbook of Practical Psychopharmacology
£98.80
Whsmith.co.uk
Free Delivery

£13.95
amazon.co.uk
Free Delivery

Urgent and Out-of-Hours Primary Care : A practical guide for clinicians
£25.99
Whsmith.co.uk
Free Delivery

Social Prescribing : Paradigms, Perspectives and Practice
£33.24
Whsmith.co.uk
Free Delivery

Independent and Supplementary Prescribing At a Glance
£28.49
Whsmith.co.uk
Free Delivery

Practical Psychopharmacology : Basic to Advanced Principles
£33.24
Whsmith.co.uk
Free Delivery

Prescribing for Elderly Patients
£105.40
Whsmith.co.uk
Free Delivery

Essential Notes on Prescribing for Finals and Junior Doctors
£39.89
Whsmith.co.uk
Free Delivery

Urgent and Out-of-Hours Primary Care, updated edition : A practical guide for clinicians
£26.99
Whsmith.co.uk
Free Delivery

Oxford Handbook of Prescribing for Nurses and Allied Health Professionals
£28.49
Whsmith.co.uk
Free Delivery
🤖 Ask ChatGPT
🛍️ What are the most important purchase criteria?
💰 Tell me the best deals!
📋 Create a short summary!
Informations about "practical prescribing for"
Having searched the market for the cheapest prices, 108 offers were found for comparison.
Furthermore, a large number of offers in 19 relevant categories with a price range from £8.95 to £185.56 were found.
About "practical prescribing for"
- Overall, our search showed 3 different shops for your product "practical prescribing for", including Amazon-marketplace.co.uk, Whsmith.co.uk and amazon.co.uk.
- After having chosen your companies you may also choose the delivery company. 5 delivery brands are available Elsevier, University of Wisconsin Press, Taylor & Francis Group and Oxford University Press being the most popular.
- The most offers (6) were found in the price range from £21.00 to £21.99.
- Furthermore, other users were also interested in the following product: .
- Personalise your product by choosing one of the 0 shades.
Don't forget your voucher code:
Report Illegal Concerns
You are about to report a violation based on the EU Digital Services Act (DSA).